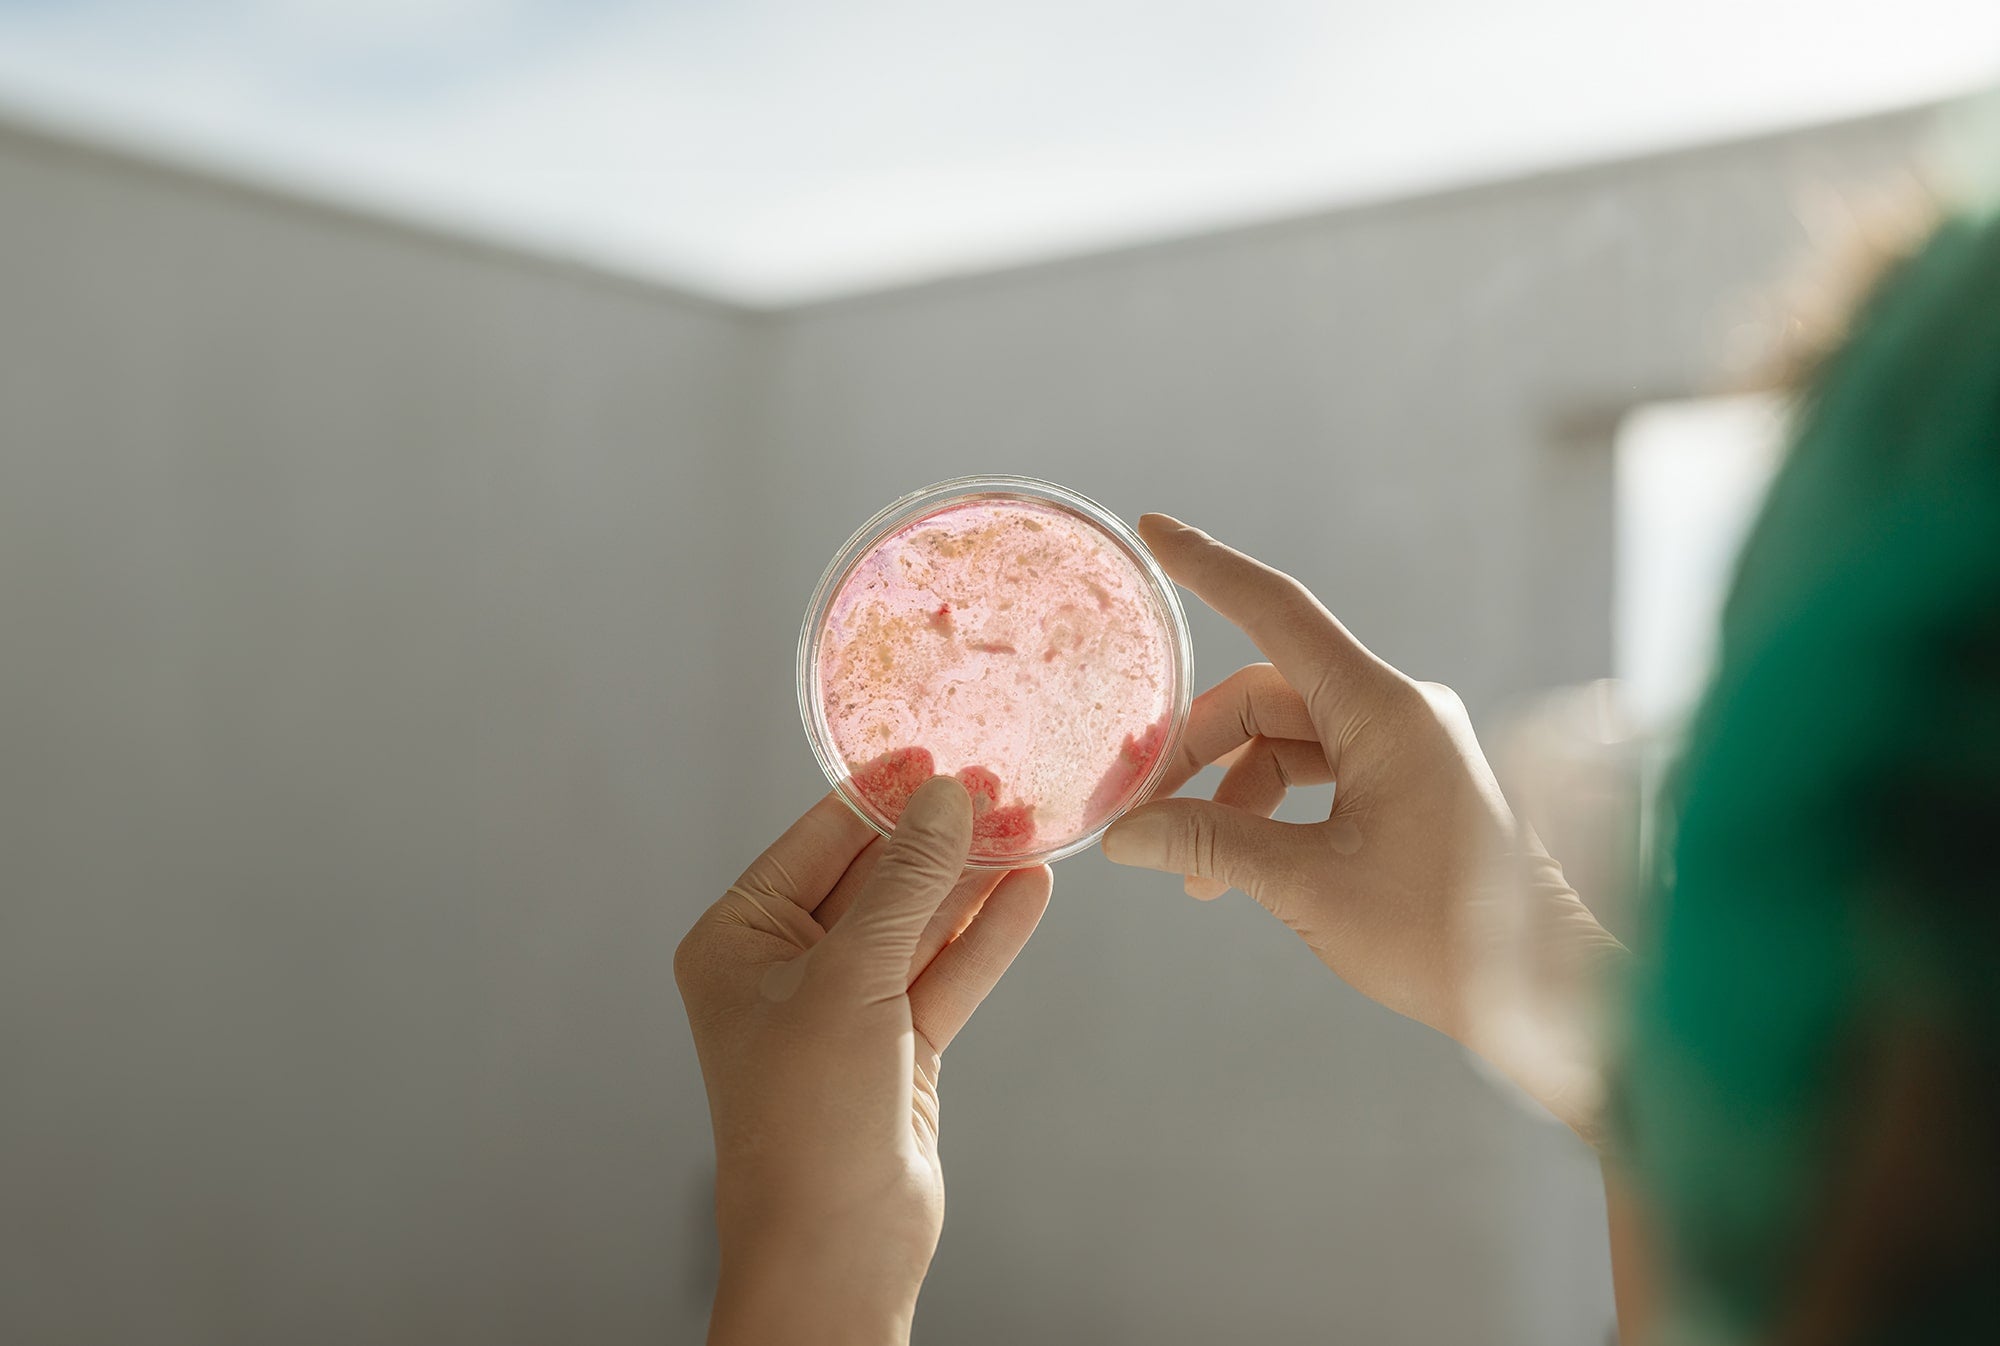
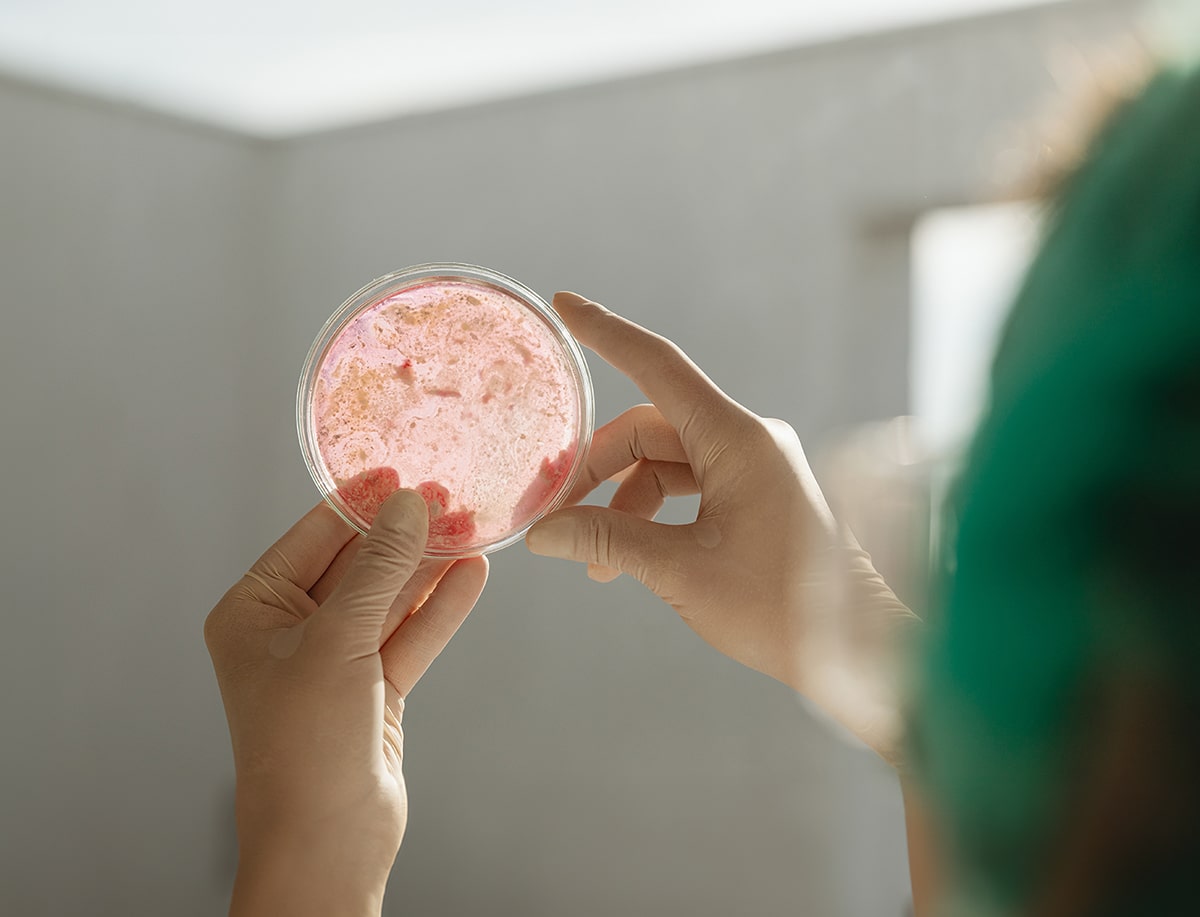

Im Fokus
Das Mikrobiom des Menschen
Das Mikrobiom des Menschen, das heißt die Bakterien, die physiologisch (also nicht krankmachend) in unserem Körper leben, umfasst 39 Billionen Mikroorganismen! Der Großteil dieser Bakterien (70 %) ist dabei in unserem Dickdarm angesiedelt. Während sich auf den Milliliter gerechnet mehr als 1.000.000.000 Bakterien im Dickdarm befinden, beherbergt unser Dünndarm mit 1.000 Bakterien pro Milliliter vergleichsweise wenige Mikroorganismen. Die Bakterien des Dickdarms erfüllen eine Vielzahl nützlicher Funktionen. Sie helfen unserem Körper zum Beispiel, Nahrungsbestandteile weiter aufzuspalten und abzubauen und sogar Vitamine zu produzieren.

Small Intestinal Bacterial Overgrowth
Der Dünndarm im Ungleichgewicht
Bei SIBO (Small intestinal bacterial overgrowth), auch Dünndarmfehlbesiedelung genannt, handelt es sich um eine übermäßige Besiedlung des sonst eher keimarmen Dünndarms mit Bakterien. Die Forschung hat gezeigt, dass diese Bakterien meist den Bakterienstämmen, welche eigentlich nur im Dickdarm vorkommen, entsprechen. Im Dünndarm verstoffwechseln die exzessiv vorhandenen Bakterien die Nahrungsbestandteile, die eigentlich von unserem Körper aufgenommen werden sollen und greifen die Darmschleimhaut an. Dabei produzieren sie Gase wie Wasserstoff und Methan, die auch zu den SIBO-typischen Beschwerden führen können. Dabei handelt es sich um dieselben Gase, die sich mittels unseres Atemtests nachweisen lassen.

SIBO
Symptome und Folgen
Bei zwei Dritteln der Betroffenen treten die für SIBO typischen Symptome wie abdominellen Schmerzen, Blähungen, Blähbauch, Verstopfungen und/oder Durchfall als Folge der Dünndarmfehlbesiedlung auf. Darüber hinaus können die Bakterien indirekt auch andere Organsysteme schädigen und z. B. zu Unterernährung, Gewichtsverlust, Mangel an Vitamin B12 und D sowie Eisen, Blutarmut, einer erhöhten Durchlässigkeit der Darmschleimhaut (leaky gut), Müdigkeit, Kopfschmerzen, Übelkeit, Konzentrationsstörungen und vielen weiteren Krankheitsbildern führen. Eine Übersicht über relevante Studien zu assoziierten Erkrankungen bei SIBO haben wir für Euch zusammengestellt.
SIBO in der Wissenschaft

Laut Studien
Häufigste Reizdarmursache
Studien belegen, dass die Prävalenz, also die Häufigkeit des Reizdarmsyndroms (RDS) in der deutschen Bevölkerung, bei 16,6 % liegt – es handelt sich also um eine Volkskrankheit. Die Diagnose RDS wird als Ausschlussdiagnose gestellt: Das heißt es müssen zuerst die häufigsten Erkrankungen mit ähnlichem Beschwerdebild ausgeschlossen werden. Bleiben die gängigen Untersuchungen ohne Befund, werden die Betroffenen oft mit einer psychischen Erklärung Ihrer Beschwerden vertröstet. Viele fühlen sich dadurch nicht ernst genommen und allein gelassen.
Dabei wird leider viel zu häufig übersehen, dass SIBO die Ursache der Beschwerden sein könnte. Und das obwohl ca. 60 % der Reizdarmbetroffenen eigentlich SIBO haben! Die Verbindung zwischen dem RDS und SIBO ist bereits gut erforscht und mit Studien belegt. SIBO ist also ein unterschätztes Krankheitsbild, an dem viele Menschen leiden und das häufig unerkannt bleibt. Die gute Nachricht ist: Wurde SIBO erst einmal festgestellt, kann sie therapiert werden.
Wie kann SIBO nachgewiesen werden?
Eine Möglichkeit, die bakterielle Fehbesiedlung des Dünndarms zu diagnostizieren, ist das sogenannte Jejunumaspirat: Hier wird mit einem Endoskop Flüssigkeit aus dem Dünndarm (Jejunum) entnommen und auf Bakterien untersucht. Lassen sich mehr als 103(bzw. früher 105) Bakterien pro Bakterienkolonie in einer Kultur nachweisen, deutet dies auf SIBO hin. Allerdings können hierbei nur die ersten 60 cm des insgesamt 5 m langen Dünndarms untersucht werden, sodass sich tiefergelegene Fehlbesiedlungen nicht nachweisen lassen. Zudem ist die Methode mit eingriffsbedingten Risiken verbunden.
In der Praxis und Forschung wird daher der Glukose- und Laktulose-Atemtest zur Diagnose der bakteriellen Fehlbesiedlung (SIBO) angewendet: Nach der Einnahme einer Zuckerlösung (Glukose oder Laktulose) verstoffwechseln die Bakterien die Kohlenhydrate im Dünndarm und produzieren dabei Gase wie Wasserstoff und Methan. Diese Gase gelangen in die Blutbahn, werden über die Lunge abgeatmet und lassen sich dann mit unserem Atemgastest nachweisen. In den amerikanischen Leitlinien wird der Atemgastest als „günstige, nicht invasive, einfach zu handhabende und allerorts verfügbare“ Methode als Mittel der Wahl zur Diagnose von SIBO bewertet. Atemgastests werden nicht nur zur Diagnose sondern auch zur Verlaufsbeurteilung von SIBO, z. B. nach einer Therapie, verwendet (sogenannter Folgetest).













SIBO Test
inkl. MwSt. zzgl. Versand, kostenfrei ab 49 € in DE
Unser SIBO Test hilft Dir, die Ursache Deiner Verdauungsbeschwerden aufzudecken, sodass Du diese gezielt angehen und loswerden kannst. Denn Studien zufolge haben über 60 % der Menschen mit Reizdarmbeschwerden SIBO. Viele unserer Kunden entscheiden sich anschließend für unsere pflanzliche SIBO Darmkur. Auch Ärzte, Heilpraktiker und Apotheker setzen auf den Test und unsere Produkte. Die wichtigsten Details:
- Laktulose Atemtest für Zuhause mit Analyse im Partnerlabor
- Aussagekräftiger Atemgastest für Dünndarmfehlbesiedlung (SIBO) und Überwucherung mit methanproduzierenden Keimen (IMO)
- Präzise Messung von Wasserstoff (H₂), Methan (CH₄) und CO₂ in Deiner Atemluft
- Analyse von Dünn- und Dickdarm über 180-Minuten-Zeitraum
- Verständliche Testergebnisse sowie hilfreiche Zusatzinformationen
- Kostenfreier Bonus: Du kannst Dein Ergebnis telefonisch mit unseren Experten besprechen

Bakterien beseitigen, Ursachen finden, Symptome lindern und Rückfälle vermeiden
SIBO Therapie
Die Therapie der Dünndarmfehlbesiedlung ist komplex und sollte immer auch die Ursache der Beschwerden berücksichtigen. Langfristige Therapieerfolge werden oft erst durch die Kombination mehrerer Behandlungsansätze erreicht. Ohne Anspruch auf Vollständigkeit haben wir im Folgenden zur Übersicht etablierte Behandlungsansätze zusammengefasst. Zu vielen der Behandlungsansätzen gibt es bereits aufschlussreiche Studien. Die Dünndarmfehlbesiedlung ist in den letzten Jahren immer mehr in den Fokus der Wissenschaft gerückt, sodass sich die Forschung zur Diagnostik und Therapie von SIBO ständig weiterentwickelt und neue Erkenntnisse generiert. Die unten genannten Therapieaspekte ergänzen und überlappen sich in vielen Bereichen, was noch einmal die Notwendigkeit eines ganzheitlichen Ansatzes zur Behandlung einer Dünndarmfehlbesiedlung unterstreicht.
Wissenswertes
Auslöser und Risikofaktoren
Obwohl noch nicht alle Ursachen der Dünndarmfehlbesiedlung vollkommen erforscht sind, gibt es zahlreiche Studien, in denen Auslöser und Risikofaktoren identifiziert wurden. Unser Körper verfügt über eigene Schutzmechanismen, welche die übermäßige Besiedlung des Dünndarms mit Bakterien verhindern sollen. Ist eine oder mehrere dieser Funktionen gestört, können sich die Bakterien im Dünndarm vermehren. Kann die Ursache der Fehlbesiedlung gefunden und sogar behoben werden, wird ein Rückfall dadurch unwahrscheinlicher.
Häufigste Auslöser
- Zu wenig Magensäure (z. B. durch Einnahme von Magensäureblockern oder eine bakterielle Infektion (H. pylori) des Magens)
- Eine verminderte Beweglichkeit des Dünndarms (z. B. durch Störung eines dünndarmeigenen Reinigungsmechanismus, auch Migrating motor complex genannt, oder chronische Erkrankungen)
- Lebensmittelvergiftungen
- Störungen der physiologischen Barriere zwischen Dick- und Dünndarm (Ileozökalklappe). Ist diese defekt, können Dickdarminhalte und damit Bakterien einfach in den Dünndarm gelangen
- Erkrankungen der Gallenwege oder der Bauchspeicheldrüse
- Anatomische Veränderungen (z. B. nach Darmoperationen)
- Immunschwäche
SIBO und andere Krankheiten
Neben dem Reizdarmsyndrom gibt es weitere Erkrankungen, die häufig in Verbindung mit SIBO beobachtet werden. Einige Krankheitsbilder können Ursache, andere Folgeerscheinung der Dünndarmfehlbesiedlung sein. Andere Erkrankungen treten gehäuft neben SIBO auf, ohne dass der zugrundeliegende Mechanismus schon vollständig verstanden ist.
Ein in Studien gut erforschter ursächlicher Zusammenhang besteht beispielsweise zwischen SIBO und Diabetes mellitus: Durch hohe Blutzuckerspiegel werden die Nerven des Darms geschädigt (autonome Neuropathie), wodurch sekundär die Motilität (Bewegungsvermögen) des Verdauungstraktes vermindert wird. Die daraus resultierende beeinträchtigte Reinigungsfunktion des Darms begünstigt dann die Ansiedlung von Bakterien.
In anderen Fällen, wie z.B. bei Nahrungsmittelunverträglichkeiten, ist die Schleimhaut des Darms durch die Bakterien so stark angegriffen, dass Nahrungsbestandteile nicht mehr aufgenommen werden können. Wird SIBO erfolgreich behandelt, kann der Darm seine Funktion wieder aufnehmen und auch die vorher nicht vertragenen Nahrungsbestandteile wieder verwerten – ganz ohne Darmbeschwerden.










